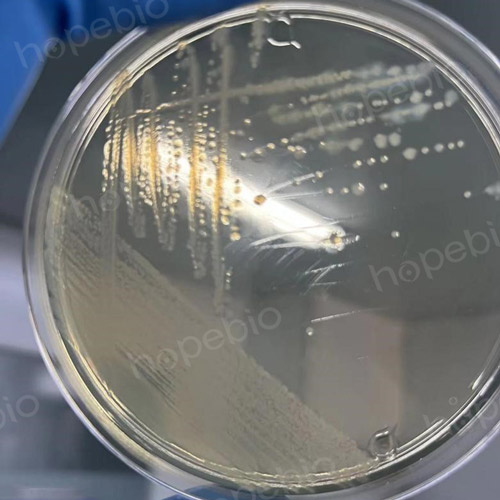
迁徙生长导致菌落分离困难
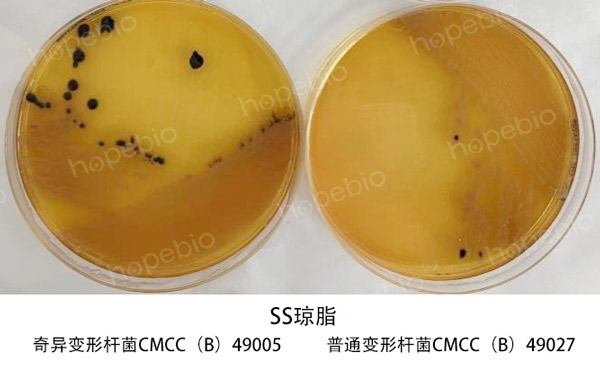
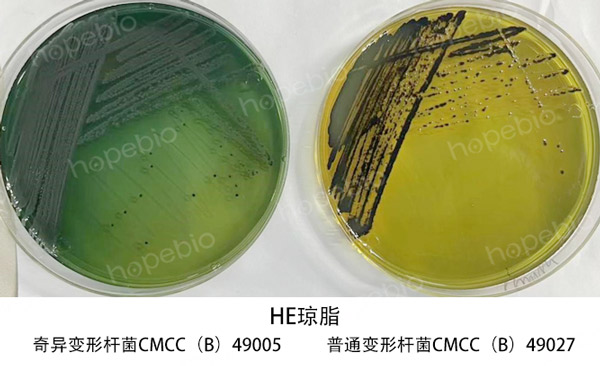
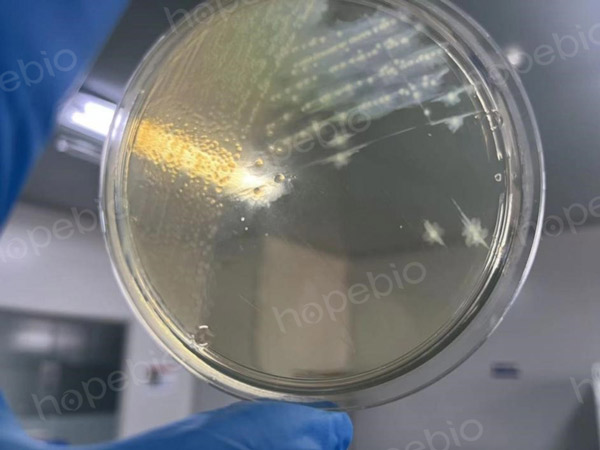
普通变形杆菌CMCC(B)49027
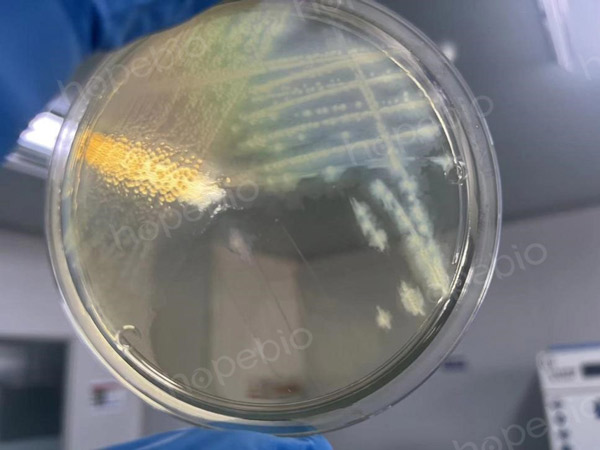
奇异变形杆菌CMCC（B）49005
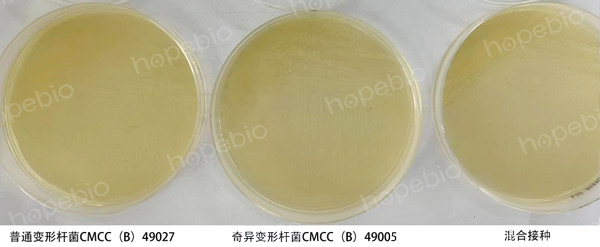
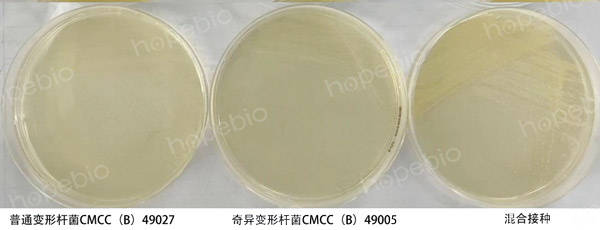
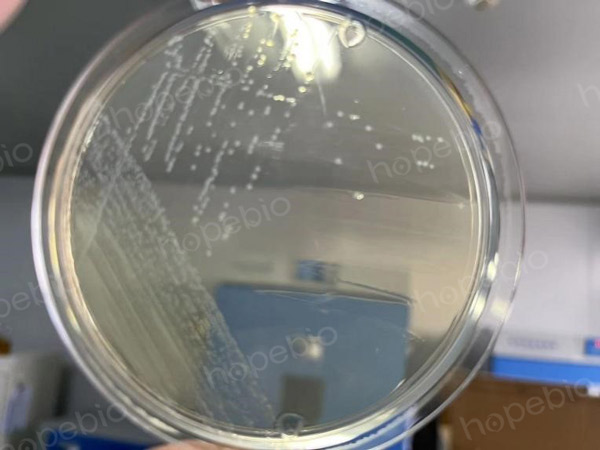
奇异变形杆菌CMCC（B）49005无迁徙生长现象
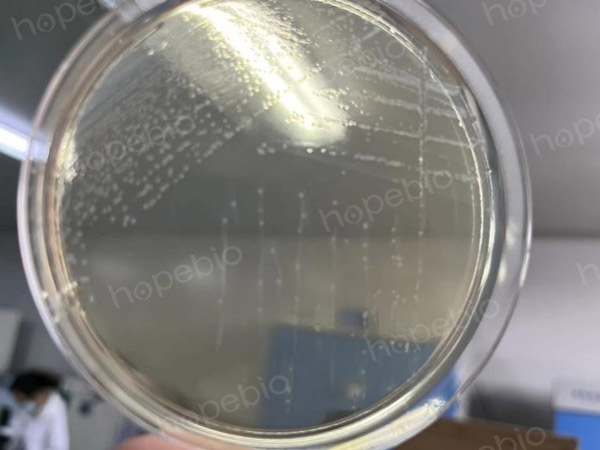
普通变形杆菌CMCC（B）49027

海博微信公众号
海博微信公众号
 海博天猫旗舰店
海博天猫旗舰店


 海博微信公众号
海博微信公众号
 海博天猫旗舰店
海博天猫旗舰店




变形杆菌属是常见的肠杆菌科细菌之一,其为革兰氏阴性菌,有鞭毛,无荚膜,无芽孢,运动活泼。与临床和食品检验较为密切的为普通变形杆菌与奇异变形杆菌。在固体培养基表面常扩散生长,最终形成迁徙生长的现象。

普通变形杆菌CMCC(B)49027在TSA平皿上的迁徙生长
迁徙生长是指细菌在固体培养基上呈扩散性生长,形成以细菌接种部位为中心的厚薄交替,同心圆型的层层波状菌苔。
因为变形杆菌的迁徙生长现象,使得在划线分离变形杆菌的过程中,很难分离出变形杆菌的单菌落。同时,若检测样品污染了变形杆菌,则很容易出现变形杆菌菌苔包围了其他细菌单菌落,出现分离其他细菌单菌落困难的现象。
迁徙生长导致菌落分离困难
方法:
1.使用含有胆盐的琼脂
含有胆盐、脱氧胆酸盐的培养基可以抑制变形杆菌的迁徙生长,且胆盐对革兰氏阳性菌有抑制作用。适合用来分离各种革兰氏阴性菌。常用的含胆盐培养基有麦康凯琼脂、HE琼脂、SS琼脂等。
普通变形杆菌和奇异变形杆菌在HE琼脂和SS琼脂上形成单菌落,无迁徙生长现象。同时各种不同的显色反应也可以分辨变形杆菌和其他革兰氏阴性菌。

2.在培养基中添加0.4%硼酸
以TSA为例,在配制时向TSA中添加0.4%的硼酸,121℃灭菌15min后倒平皿。划线接种普通变形杆菌,奇异变形杆菌。同时划线接种大肠杆菌,沙门氏菌,普通变形杆菌的混合菌液。
在36℃需氧培养18小时后,观察结果。
可以看出培养基添加硼酸后抑菌性很强,18小时后只有一区生长,变形杆菌可以形成单菌落。延长培养时间后,可观察到二区三区生长,出现单菌落。但此方法需要培养时间较长,容易导致培养基失水,且硼酸具有抑菌性,可能会使目标菌不生长。

3.含0.1%苯酚TSA
以TSA为例,在配制时向TSA中添加0.1%的苯酚(石碳酸),121℃灭菌15min后倒平皿。划线接种普通变形杆菌,奇异变形杆菌。同时划线接种大肠杆菌,沙门氏菌,普通变形杆菌的混合菌液。
在36℃需氧培养18小时后,观察结果。
观察结果时可以发现本平皿抑菌性很强,一区微弱生长出单菌落,延长培养时间后可见二三区出现单菌落。苯酚作为抑菌成分,可能会使目标菌不生长,同时苯酚对人体具有毒性,具有刺激性气味。因此笔者不推荐使用此方法。

4.95%乙醇
在普通TSA平皿表面,倾倒适量95%乙醇。在整个培养皿表面都接触酒精后,将酒精倒出,使用超净工作台吹风将平皿表面吹干。划线接种普通变形杆菌,奇异变形杆菌。同时划线接种大肠杆菌,沙门氏菌,普通变形杆菌的混合菌液。
在36℃需氧培养18小时后,观察结果。
可以看到此法有一定效果,但不能显著抑制其迁徙生长,在短时间培养时,可以在三区分离出单菌落。当延长培养时间后,变形杆菌仍会迁徙生长蔓延整个培养基表面。相对而言,本法较为简单,也具有一定的效果,从混合接种的结果来看,对本次混合的菌种并无抑制作用。
普通变形杆菌CMCC(B)49027
奇异变形杆菌CMCC(B)49005
5.使培养基含有10%琼脂
以TSA为例,在配制时,加入10%含量的琼脂。121℃灭菌15min后倒平皿。划线接种,36℃培养18h后观察结果。
从结果来看,变形杆菌可以形成单菌落,且延长培养也不会让其迁徙生长。但是此法弊病较多。首先,商业培养基一般添加1.5%的琼脂,过高的琼脂含量,会使得培养基硬度过大,影响菌落形态。其次,添加琼脂过多,极易在加热和灭菌过程中出现糊锅的情况。且最终状态过于粘稠,流动性很差,本次试验倒平皿时,培养基呈蜜糖状,很难控制倒出的培养基量。
6.调整培养基中氯化钠含量
在配制培养基时,可以调整培养基中的氯化钠含量。本次试验以无盐TSA以及甘露醇氯化钠琼脂(氯化钠含量7.5%)为例。划线接种36℃需氧培养18h后观察结果。
无盐TSA以及甘露醇氯化钠琼脂上,变形杆菌均不迁徙生长。在甘露醇氯化钠琼脂上,变形杆菌呈针尖大小。若样本的目标菌是金黄色葡萄球菌,变形杆菌为干扰菌,则推荐使用甘露醇氯化钠琼脂(或B-P琼脂)。

在无盐TSA上,变形杆菌菌落较甘露醇氯化钠琼脂上大。但是现在商品化培养基一般均添加了氯化钠成分,若需要无盐琼脂,则多数情况下需要定制或自己使用原料配制,使用不方便。
7.微需氧/厌氧环境下培养
将变形杆菌点种至TSA平皿,36℃微需氧培养18h后,观察结果。
在微需氧环境中,变形杆菌仍会出现迁徙生长的现象。

将变形杆菌划线接种TSA平皿,36℃厌氧培养18h后,观察结果。
在厌氧培养的条件下,普通变形杆菌仍有轻微的迁徙生长,奇异变形杆菌则无迁徙生长的现象。
奇异变形杆菌CMCC(B)49005无迁徙生长现象
普通变形杆菌CMCC(B)49027
相关产品:
注:本文属海博生物原创,未经允许不得转载。
上一篇:黑曲霉的活化、保存及孢子悬液制备
| 相关文章: | ||



